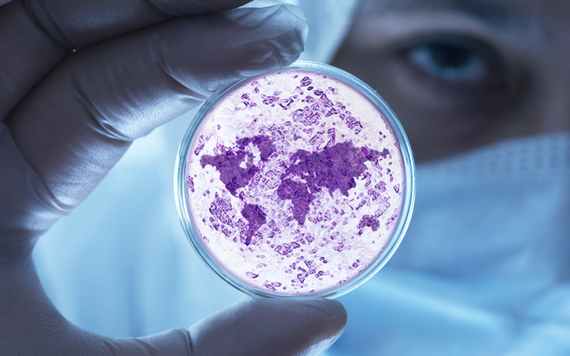

There's a devastating epidemic spreading across the world that is being ignored by world leaders. One that, since the 1980s, has been spiralling out of control and now affects over 600 million people worldwide. To put this into perspective, in 2014, nearly three times more people had this condition than contracted malaria.
This epidemic is hitting people of all ages, from all parts of society and from most countries worldwide. No one is immune to it and there is no simple vaccine or quick fix. The frightening thing about it is that it increases people's risk of developing some of this world's deadliest diseases including 11 common cancers, diabetes and heart disease. Beating this epidemic can also be hard as it doesn't only affect us physically but also affects us mentally.
Governments around the world have the power to fight this epidemic but so far very few have done anything about it. Instead they often give in to pressure from some of the companies who have helped feed it.
You'll find that many of the factors that contribute to this epidemic are being advertised on our television screens, on billboards and at sports games, often without us even realising it. And, worst of all, our children are being targeted. Across the world, around 41 million children under the age of five are either at the early stages of the condition or are already severely affected. You might be shocked to know that some of our children's favourite cartoon characters are being used to manipulate our little ones. This is all helping fuel the epidemic so that it continues to spread for generations to come.
Whilst humans are vulnerable to the epidemic, thankfully there are ways to protect ourselves, but this takes conscious decisions from all members of society to beat it - from decision makers and health professionals to individuals.
Governments must start taking this epidemic seriously before it spirals further out of our control. Health professionals are telling us that they often aren't being given the training they need to deal with it, but this could be easily remedied if they were properly equipped.
People can also start reducing their own risk of developing the condition by simply eating plenty of fresh fruit and vegetables, cutting out the amount of junk food they eat and exercising at least 30 minutes a day. If people have already been affected they should also follow these recommendations. There are also organisations like the World Cancer Research Fund who have stepped in to ensure that information is available to help people beat this epidemic.
Only by working together can we beat this epidemic - obesity.